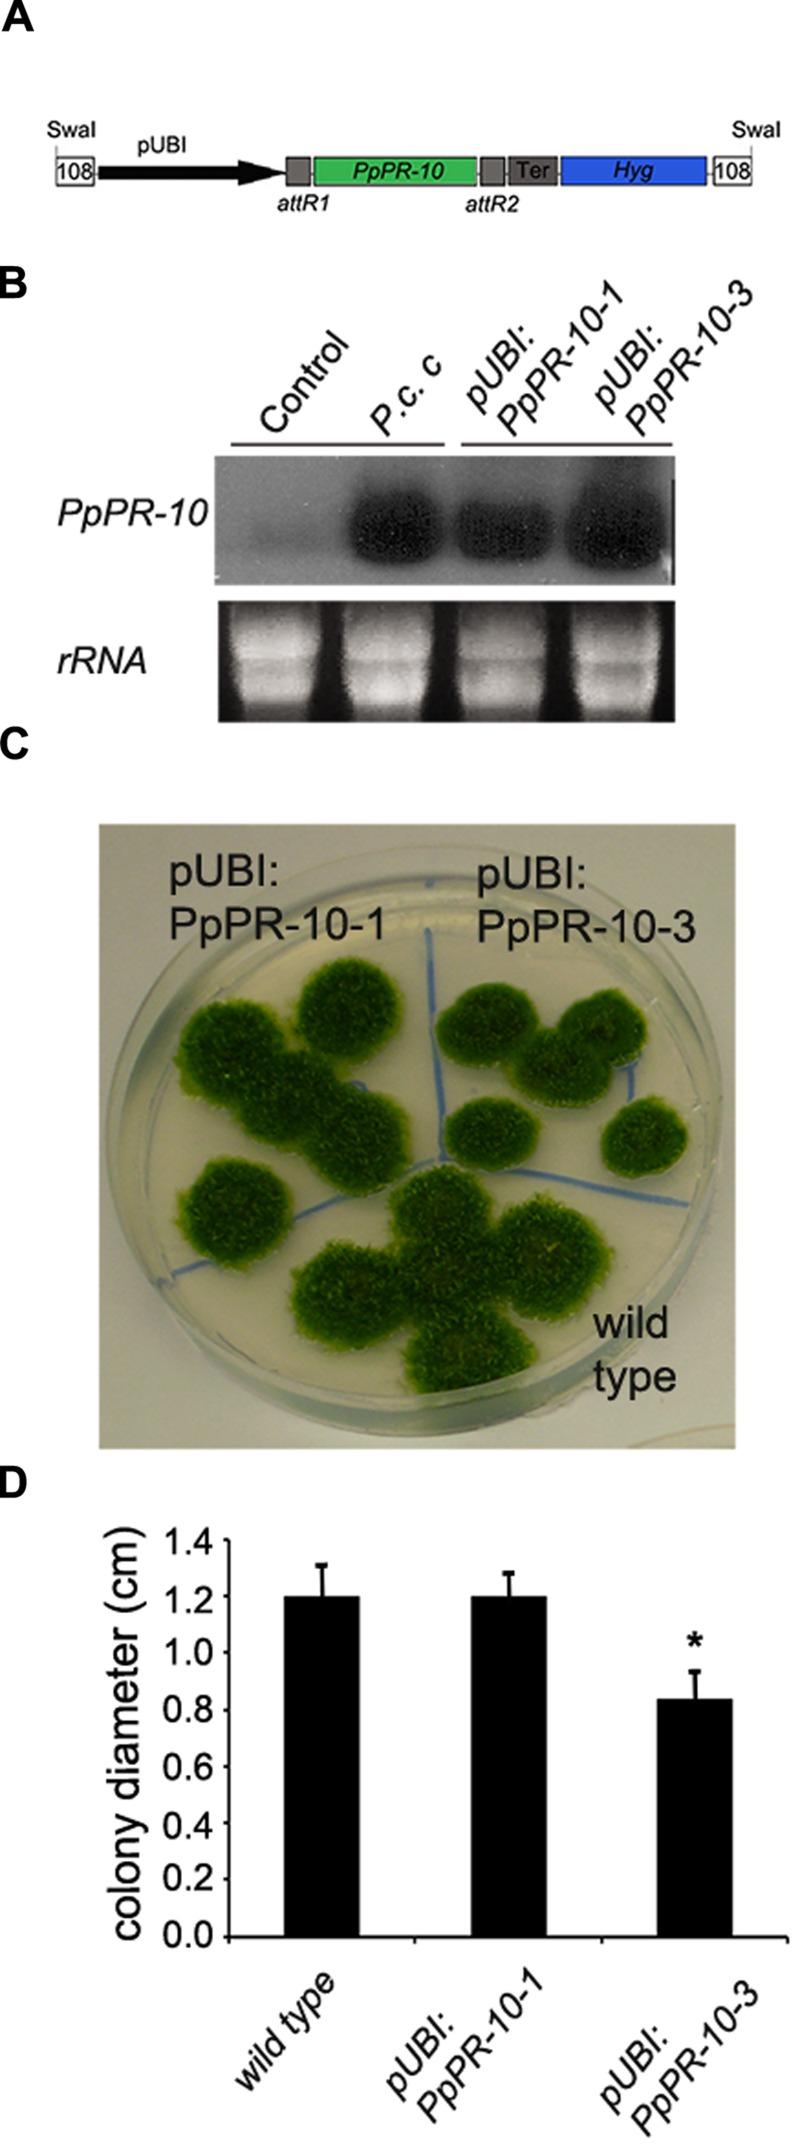

苔藓病程相关蛋白10增强了小立碗藓和拟南芥对不规则腐霉的抗性。
Moss Pathogenesis-Related-10 Protein Enhances Resistance to Pythium irregulare in Physcomitrella patens and Arabidopsis thaliana.
作者信息
Castro Alexandra, Vidal Sabina, Ponce de León Inés
机构信息
Departamento de Biología Molecular, Instituto de Investigaciones Biológicas Clemente EstableMontevideo, Uruguay; Laboratorio de Biología Molecular Vegetal, Facultad de Ciencias, Universidad de la RepúblicaMontevideo, Uruguay.
Laboratorio de Biología Molecular Vegetal, Facultad de Ciencias, Universidad de la República Montevideo, Uruguay.
出版信息
Front Plant Sci. 2016 Apr 29;7:580. doi: 10.3389/fpls.2016.00580. eCollection 2016.
Plants respond to pathogen infection by activating signaling pathways leading to the accumulation of proteins with diverse roles in defense. Here, we addressed the functional role of PpPR-10, a pathogenesis-related (PR)-10 gene, of the moss Physcomitrella patens, in response to biotic stress. PpPR-10 belongs to a multigene family and encodes a protein twice the usual size of PR-10 proteins due to the presence of two Bet v1 domains. Moss PR-10 genes are differentially regulated during development and inoculation with the fungal pathogen Botrytis cinerea. Specifically, PpPR-10 transcript levels increase significantly by treatments with elicitors of Pectobacterium carotovorum subsp. carotovorum, spores of B. cinerea, and the defense hormone salicylic acid. To characterize the role of PpPR-10 in plant defense against pathogens, we conducted overexpression analysis in P. patens and in Arabidopsis thaliana. We demonstrate that constitutive expression of PpPR-10 in moss tissues increased resistance against the oomycete Pythium irregulare. PpPR-10 overexpressing moss plants developed less symptoms and decreased mycelium growth than wild type plants. In addition, PpPR-10 overexpressing plants constitutively produced cell wall depositions in protonemal tissue. Ectopic expression of PpPR-10 in Arabidopsis resulted in increased resistance against P. irregulare as well, evidenced by smaller lesions and less cellular damage compared to wild type plants. These results indicate that PpPR-10 is functionally active in the defense against the pathogen P. irregulare, in both P. patens and Arabidopsis, two evolutionary distant plants. Thus, P. patens can serve as an interesting source of genes to improve resistance against pathogen infection in flowering plants.
植物通过激活信号通路来应对病原体感染,这些信号通路会导致在防御中发挥不同作用的蛋白质积累。在此,我们探讨了小立碗藓中一个病程相关(PR)-10基因PpPR-10在应对生物胁迫时的功能作用。PpPR-10属于一个多基因家族,由于存在两个Bet v1结构域,其编码的蛋白质大小是PR-10蛋白通常大小的两倍。苔藓PR-10基因在发育过程以及接种真菌病原体灰葡萄孢时受到不同的调控。具体而言,用胡萝卜软腐果胶杆菌胡萝卜软腐亚种的激发子、灰葡萄孢的孢子以及防御激素水杨酸处理后,PpPR-10转录水平显著增加。为了表征PpPR-10在植物抵御病原体中的作用,我们在小立碗藓和拟南芥中进行了过表达分析。我们证明,PpPR-10在苔藓组织中的组成型表达增强了对卵菌不规则腐霉的抗性。与野生型植物相比,过表达PpPR-10的苔藓植物出现的症状更少,菌丝体生长也减少。此外,过表达PpPR-10的植物在原丝体组织中组成型地产生细胞壁沉积物。PpPR-10在拟南芥中的异位表达也导致对不规则腐霉的抗性增强,与野生型植物相比,病斑更小,细胞损伤更少,这证明了这一点。这些结果表明,PpPR-10在小立碗藓和拟南芥这两种进化关系较远的植物中,对抵御病原体不规则腐霉具有功能活性。因此,小立碗藓可以作为一个有趣的基因来源,用于提高开花植物对病原体感染的抗性。